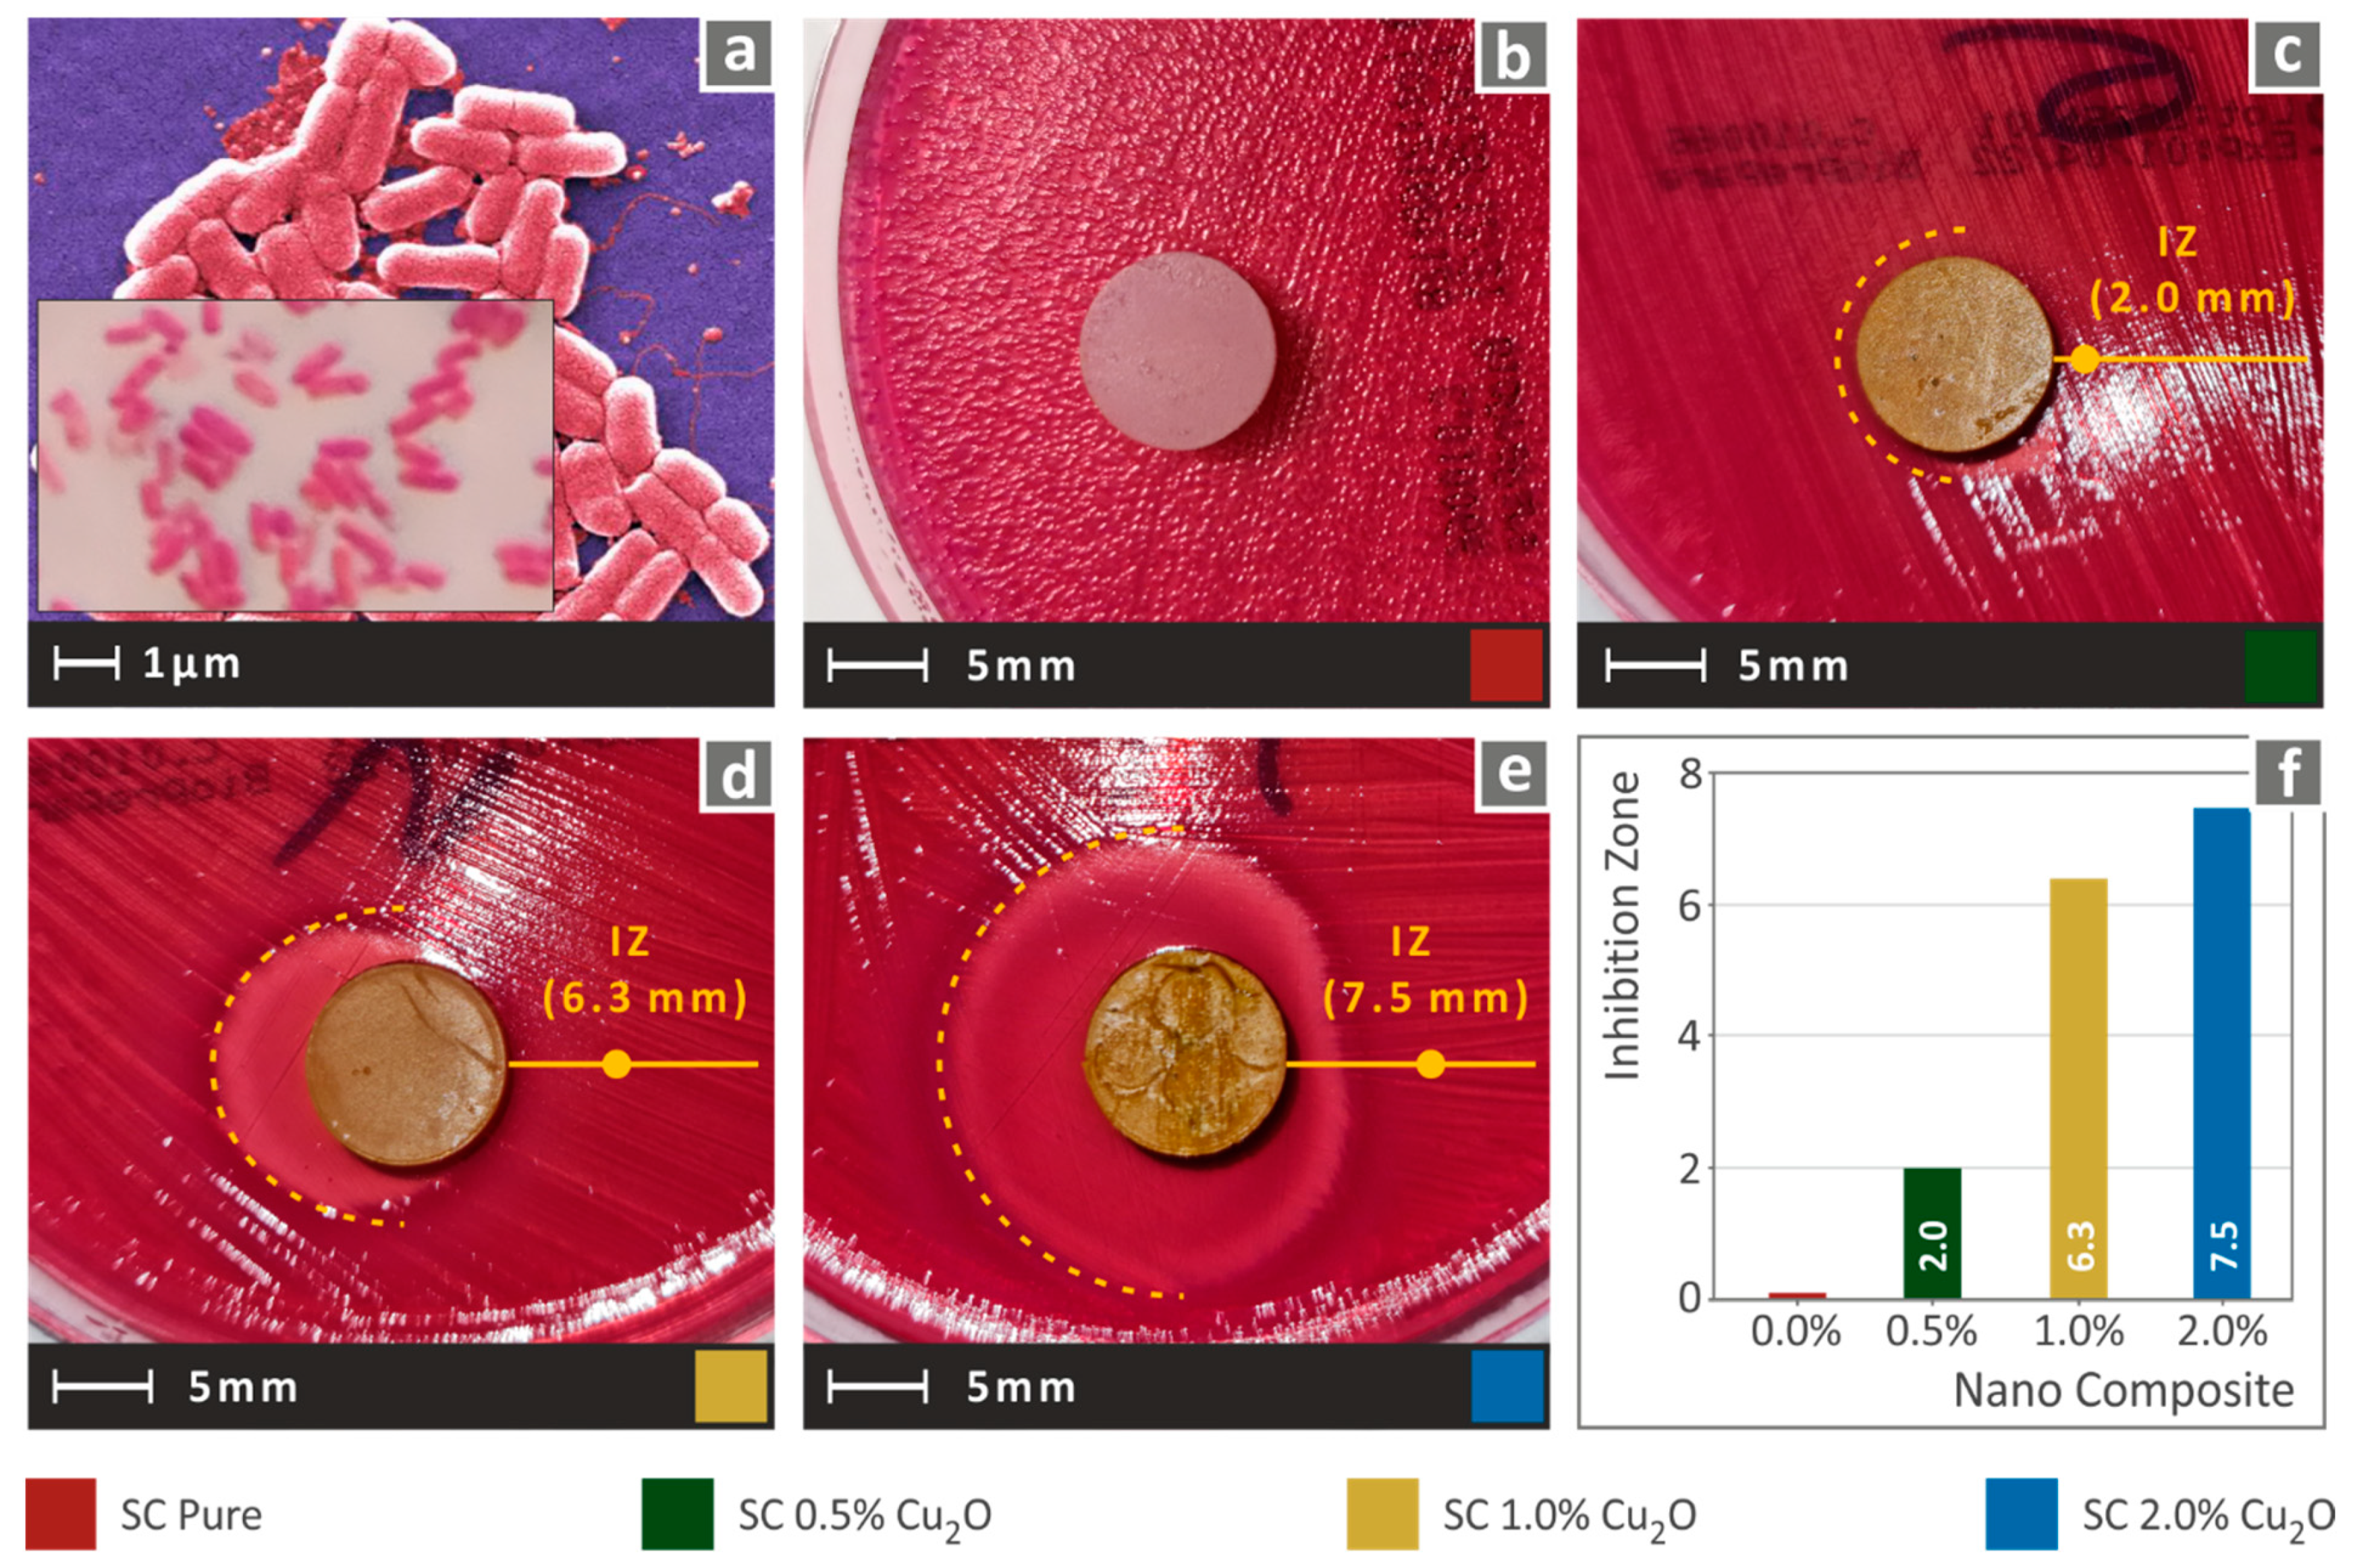
Biomimetics 07 00012 g008

Affordable Biocidal Ultraviolet Cured Cuprous Oxide Filled Vat Photopolymerization Resin Nanocomposites with Enhanced Mechanical Properties
Abstract
:1. Introduction
2. Materials and Methods
2.1. Materials
2.2. Nanocomposites and Specimens Fabrication
2.3. Mechanical Performance Testing
2.4. Morphological, Thermal, and Antibacterial Analysis
3. Results
3.1. Mechanical Performance Analysis
3.2. Thermal, Morphological, and Antibacterial Analysis
3.2.1. Thermal Analysis
3.2.2. Morphological Analysis
3.2.3. Nanocomposites Biocidal Performance
4. Discussion
5. Conclusions
Author Contributions
Funding
Institutional Review Board Statement
Informed Consent Statement
Data Availability Statement
Acknowledgments
Conflicts of Interest
References
- Chee, E.; Brown, A.C. Biomimetic antimicrobial material strategies for combating antibiotic-resistant bacteria. Biomater. Sci. 2020, 8, 1089–1100. [Google Scholar] [CrossRef]
- Raffi, M.; Mehrwan, S.; Bhatti, T.M.; Akhter, J.I.; Hameed, A.; Yawar, W.; Ul Hasan, M.M. Investigations into the antibacterial behavior of copper nanoparticles against Escherichia coli. Ann. Microbiol. 2010, 60, 75–80. [Google Scholar] [CrossRef]
- Ergene, C.; Yasuhara, K.; Palermo, E.F. Biomimetic antimicrobial polymers: Recent advances in molecular design. Polym. Chem. 2018, 9, 2407–2427. [Google Scholar] [CrossRef] [Green Version]
- Slavin, Y.N.; Asnis, J.; Häfeli, U.O.; Bach, H. Metal nanoparticles: Understanding the mechanisms behind antibacterial activity. J. Nanobiotechnol. 2017, 15, 1–20. [Google Scholar] [CrossRef] [PubMed]
- Chatterjee, A.K.; Chakraborty, R.; Basu, T. Mechanism of antibacterial activity of copper nanoparticles. Nanotechnology 2014, 25, 135101. [Google Scholar] [CrossRef]
- Liu, J.; Wu, D.; Zhu, N.; Wu, Y.; Li, G. Antibacterial mechanisms and applications of metal-organic frameworks and their derived nanomaterials. Trends Food Sci. Technol. 2021, 109, 413–434. [Google Scholar] [CrossRef]
- Savolainen, J.; Collan, M. How Additive Manufacturing Technology Changes Business Models?—Review of Literature. Addit. Manuf. 2020, 32, 101070. [Google Scholar] [CrossRef]
- Vairis, A.; Petousis, M.; Vidakis, N.; Savvakis, K. On the Strain Rate Sensitivity of Abs and Abs Plus Fused Deposition Modeling Parts. J. Mater. Eng. Perform. 2016, 25, 3558–3565. [Google Scholar] [CrossRef]
- Dilberoglu, U.M.; Gharehpapagh, B.; Yaman, U.; Dolen, M. The Role of Additive Manufacturing in the Era of Industry 4.0. Procedia Manuf. 2017, 11, 545–554. [Google Scholar] [CrossRef]
- Valvez, S.; Santos, P.; Parente, J.M.; Silva, M.P.; Reis, P.N.B. 3D Printed Continuous Carbon Fiber Reinforced PLA Composites: A Short Review. Procedia Struct. Integr. 2020, 25, 394–399. [Google Scholar] [CrossRef]
- Chinthavali, M. 3D Printing Technology for Automotive Applications. In Proceedings of the 3D-PEIM 2016–2016 International Symposium on 3D Power Electronics Integration and Manufacturing, Raleigh, CA, USA, 21–23 June 2016. [Google Scholar]
- Yelamanchi, B.; Mummareddy, B.; Santiago, C.C.; Ojoawo, B.; Metsger, K.; Helfferich, B.; Zapka, J.; Sillani, F.; MacDonald, E.; Cortes, P. Mechanical and Fatigue Performance of Pressurized Vessels Fabricated with Multi Jet FusionTM for Automotive Applications. Addit. Manuf. 2021, 44, 102048. [Google Scholar] [CrossRef]
- Tzounis, L.; Bangeas, P.I.; Exadaktylos, A.; Petousis, M.; Vidakis, N. Three-Dimensional Printed Polylactic Acid (PLA) Surgical Retractors with Sonochemically Immobilized Silver Nanoparticles: The next Generation of Low-Cost Antimicrobial Surgery Equipment. Nanomaterials 2020, 10, 985. [Google Scholar] [CrossRef]
- Valentine, A.D.; Busbee, T.A.; Boley, J.W.; Raney, J.R.; Chortos, A.; Kotikian, A.; Berrigan, J.D.; Durstock, M.F.; Lewis, J.A. Hybrid 3D Printing of Soft Electronics. Adv. Mater. 2017, 29, 1703817. [Google Scholar] [CrossRef] [PubMed]
- Vidakis, N.; Maniadi, A.; Petousis, M.; Vamvakaki, M.; Kenanakis, G.; Koudoumas, E. Mechanical and Electrical Properties Investigation of 3D-Printed Acrylonitrile–Butadiene–Styrene Graphene and Carbon Nanocomposites. J. Mater. Eng. Perform. 2020, 29, 1909–1918. [Google Scholar] [CrossRef]
- Vidakis, N.; Petousis, M.; Savvakis, K.; Maniadi, A.; Koudoumas, E. A comprehensive investigation of the mechanical behavior and the dielectrics of pure polylactic acid (PLA) and PLA with graphene (GnP) in fused deposition modeling (FDM). Int. J. Plast. Technol. 2019, 23, 195–206. [Google Scholar] [CrossRef]
- MacDonald, E.; Salas, R.; Espalin, D.; Perez, M.; Aguilera, E.; Muse, D.; Wicker, R.B. 3D Printing for the Rapid Prototyping of Structural Electronics. IEEE Access 2014, 2, 234–242. [Google Scholar] [CrossRef]
- Bailey, C.; Stoyanov, S.; Tilford, T.; Tourloukis, G. 3D-Printing and Electronic Packaging. In Proceedings of the 2016 Pan Pacific Microelectronics Symposium, Pan Pacific 2016, Kohala Coast, HI, USA, 25–28 January 2016. [Google Scholar]
- Aspar, G.; Goubault, B.; Lebaigue, O.; Souriau, J.C.; Simon, G.; di Cioccio, L.; Brechet, Y. 3D Printing as a New Packaging Approach for MEMS and Electronic Devices. In Proceedings of the Proceedings—Electronic Components and Technology Conference, Orlando, FL, USA, 30 May–2 June 2017; pp. 1071–1079. [Google Scholar]
- Conrad, M.; de Doncker, R.W.; Schniedenharn, M.; Diatlov, A. Packaging for Power Semiconductors Based on the 3D Printing Technology Selective Laser Melting. In Proceedings of the 2014 16th European Conference on Power Electronics and Applications, EPE-ECCE Europe 2014, Lappeenranta, Finland, 26–28 August 2014. [Google Scholar]
- Tack, P.; Victor, J.; Gemmel, P.; Annemans, L. 3D-Printing Techniques in a Medical Setting: A Systematic Literature Review. BioMedical Eng. Online 2016, 15, 1–21. [Google Scholar] [CrossRef] [Green Version]
- Vidakis, N.; Petousis, M.; Velidakis, E.; Mountakis, N.; Tzounis, L.; Liebscher, M.; Grammatikos, S.A. Enhanced Mechanical, Thermal and Antimicrobial Properties of Additively Manufactured Polylactic Acid with Optimized Nano Silica Content. Nanomaterials 2021, 11, 1012. [Google Scholar] [CrossRef]
- Vidakis, N.; Petousis, M.; Velidakis, E.; Liebscher, M.; Tzounis, L. Three-Dimensional Printed Antimicrobial Objects of Polylactic Acid (PLA)-Silver Nanoparticle Nanocomposite Filaments Produced by an In-Situ Reduction Reactive Melt Mixing Process. Biomimetics 2020, 5, 42. [Google Scholar] [CrossRef]
- Sa, L.; Kaiwu, L.; Shenggui, C.; Junzhong, Y.; Yongguang, J.; Lin, W.; Li, R. 3D Printing Dental Composite Resins with Sustaining Antibacterial Ability. J. Mater. Sci. 2019, 54, 3309–3318. [Google Scholar] [CrossRef]
- Vidakis, N.; Vairis, A.; Petousis, M.; Savvakis, K.; Kechagias, J. Fused deposition modelling parts tensile strength characterisation. Acad. J. Manuf. Eng. 2016, 14, 87–94. [Google Scholar]
- Bhadeshia, H.K.D.H. Additive Manufacturing. Mater. Sci. Technol. 2016, 32, 615–616. [Google Scholar] [CrossRef] [Green Version]
- Vidakis, N.; Petousis, M.; Velidakis, E.; Liebscher, M.; Mechtcherine, V.; Tzounis, L. On the strain rate sensitivity of fused filament fabrication (Fff) processed pla, abs, petg, pa6, and pp thermoplastic polymers. Polymers 2020, 12, 2924. [Google Scholar] [CrossRef] [PubMed]
- Gebler, M.; Schoot Uiterkamp, A.J.M.; Visser, C. A Global Sustainability Perspective on 3D Printing Technologies. Energy Policy 2014, 74, 158–167. [Google Scholar] [CrossRef]
- Vidakis, N.; Petousis, M.; Velidakis, E.; Tzounis, L.; Mountakis, N.; Korlos, A.; Fischer-Griffiths, P.E.; Grammatikos, S. On the Mechanical Response of Silicon Dioxide Nanofiller Concentration on Fused Filament Fabrication 3d Printed Isotactic Polypropylene Nanocomposites. Polymers 2021, 13, 2029. [Google Scholar] [CrossRef]
- Fernandes, J.; Deus, A.M.; Reis, L.; Vaz, M.F.; Leite, M. Study of the Influence of 3D Printing Parameters on the Mechanical Properties of PLA. Proc. Int. Conf. Prog. Addit. Manuf. 2018, 2018, 547–552. [Google Scholar] [CrossRef]
- Kumar, S.; Singh, R.; Singh, M.; Singh, T.P.; Batish, A. Multi Material 3D Printing of PLA-PA6/TiO2 Polymeric Matrix: Flexural, Wear and Morphological Properties. J. Thermoplast. Compos. Mater. 2020, 0892705720953193. [Google Scholar] [CrossRef]
- Vidakis, N.; Petousis, M.; Vairis, A.; Savvakis, K.; Maniadi, A. A parametric determination of bending and Charpy’s impact strength of ABS and ABS-plus fused deposition modeling specimens. Prog. Addit. Manuf. 2019, 4, 323–330. [Google Scholar] [CrossRef]
- Dong, J.; Mei, C.; Han, J.; Lee, S.; Wu, Q. 3D Printed Poly(Lactic Acid) Composites with Grafted Cellulose Nanofibers: Effect of Nanofiber and Post-Fabrication Annealing Treatment on Composite Flexural Properties. Addit. Manuf. 2019, 28, 621–628. [Google Scholar] [CrossRef]
- Savvakis, K.; Petousis, M.; Vairis, A.; Vidakis, N.; Bikmeyev, A. Imece2014-37553 Deposition Modeling Parts. ASME 2014 Int. Mech. Eng. Congr. Expo. 2014, 14, V014T11A022. [Google Scholar]
- Vidakis, N.; Petousis, M.; Tzounis, L.; Velidakis, E.; Mountakis, N.; Grammatikos, S.A. Polyamide 12/Multiwalled Carbon Nanotube and Carbon Black Nanocomposites Manufactured by 3D Printing Fused Filament Fabrication: A Comparison of the Electrical, Thermoelectric, and Mechanical Properties. C 2021, 7, 38. [Google Scholar] [CrossRef]
- Espera, A.H.; Valino, A.D.; Palaganas, J.O.; Souza, L.; Chen, Q.; Advincula, R.C. 3D Printing of a Robust Polyamide-12-Carbon Black Composite via Selective Laser Sintering: Thermal and Electrical Conductivity. Macromol. Mater. Eng. 2019, 304, 1800718. [Google Scholar] [CrossRef]
- Rahim, T.N.A.T.; Abdullah, A.M.; Akil, H.M.; Mohamad, D.; Rajion, Z.A. The Improvement of Mechanical and Thermal Properties of Polyamide 12 3D Printed Parts by Fused Deposition Modelling. Express Polym. Lett. 2017, 11, 963–982. [Google Scholar] [CrossRef]
- Lupone, F.; Padovano, E.; Casamento, F.; Badini, C. Process Phenomena and Material Properties in Selective Laser Sintering of Polymers: A Review. Materials 2022, 15, 183. [Google Scholar] [CrossRef]
- Goodridge, R.D.; Tuck, C.J.; Hague, R.J.M. Laser sintering of polyamides and other polymers. Prog. Mater. Sci. 2012, 57, 229–267. [Google Scholar] [CrossRef]
- Ma, X.L. Research on Application of SLA Technology in the 3D Printing Technology. Appl. Mech. Mater. 2013, 401–403, 938–941. [Google Scholar] [CrossRef]
- Mubarak, S.; Dhamodharan, D.; B. Kale, M.; Divakaran, N.; Senthil, T.; Wu, L.; Wang, J. A Novel Approach to Enhance Mechanical and Thermal Properties of SLA 3D Printed Structure by Incorporation of Metal–Metal Oxide Nanoparticles. Nanomaterials 2020, 10, 217. [Google Scholar] [CrossRef] [PubMed] [Green Version]
- Ambrosio, D.; Gabrion, X.; Malécot, P.; Amiot, F.; Thibaud, S. Influence of Manufacturing Parameters on the Mechanical Properties of Projection Stereolithography–Manufactured Specimens. Int. J. Adv. Manuf. Technol. 2020, 106, 265–277. [Google Scholar] [CrossRef] [Green Version]
- Borrello, J.; Nasser, P.; Iatridis, J.C.; Costa, K.D. 3D Printing a Mechanically-Tunable Acrylate Resin on a Commercial DLP-SLA Printer. Addit. Manuf. 2018, 23, 374–380. [Google Scholar] [CrossRef]
- Manapat, J.Z.; Chen, Q.; Ye, P.; Advincula, R.C. 3D Printing of Polymer Nanocomposites via Stereolithography. Macromol. Mater. Eng. 2017, 302, 1–13. [Google Scholar] [CrossRef]
- Kleverlaan, C.J.; Feilzer, A.J. Polymerization Shrinkage and Contraction Stress of Dental Resin Composites. Dent. Mater. 2005, 21, 1150–1157. [Google Scholar] [CrossRef] [PubMed]
- Weng, Z.; Zhou, Y.; Lin, W.; Senthil, T.; Wu, L. Structure-Property Relationship of Nano Enhanced Stereolithography Resin for Desktop SLA 3D Printer. Compos. Part A Appl. Sci. Manuf. 2016, 88, 234–242. [Google Scholar] [CrossRef]
- Martínez-Pellitero, S.; Castro, M.A.; Fernández-Abia, A.I.; González, S.; Cuesta, E. Analysis of Influence Factors on Part Quality in Micro-SLA Technology. Procedia Manuf. 2017, 13, 856–863. [Google Scholar] [CrossRef]
- Slapnik, J.; Pulko, I. Tailoring Properties of Photopolymers for Additive Manufacturing with Mixture Design. Prog. Addit. Manuf. 2021, 6, 83–91. [Google Scholar] [CrossRef]
- Chun, D.M. The Role of Technology in SLA Research. Lang. Learn. Technol. 2016, 20, 98–115. [Google Scholar]
- Advincula, R.C.; Dizon, J.R.C.; Chen, Q.; Niu, I.; Chung, J.; Kilpatrick, L.; Newman, R. Additive Manufacturing for COVID-19: Devices, Materials, Prospects, and Challenges. MRS Commun. 2020, 10, 413–427. [Google Scholar] [CrossRef]
- Tarfaoui, M.; Nachtane, M.; Goda, I.; Qureshi, Y.; Benyahia, H. Additive Manufacturing in Fighting against Novel Coronavirus COVID-19. Int. J. Adv. Manuf. Technol. 2020, 110, 2913–2927. [Google Scholar] [CrossRef]
- Tareq, M.S.; Rahman, T.; Hossain, M.; Dorrington, P. Additive Manufacturing and the COVID-19 Challenges: An in-Depth Study. J. Manuf. Syst. 2021, 60, 787–798. [Google Scholar] [CrossRef]
- Patel, P.; Gohil, P. Role of Additive Manufacturing in Medical Application COVID-19 Scenario: India Case Study. J. Manuf. Syst. 2021, 60, 811–822. [Google Scholar] [CrossRef]
- Kunovjanek, M.; Wankmüller, C. An Analysis of the Global Additive Manufacturing Response to the COVID-19 Pandemic. J. Manuf. Technol. Manag. 2020, 32, 75–100. [Google Scholar] [CrossRef]
- Larrañeta, E.; Dominguez-Robles, J.; Lamprou, D.A. Additive Manufacturing Can Assist in the Fight against COVID-19 and Other Pandemics and Impact on the Global Supply Chain. 3D Print. Addit. Manuf. 2020, 7, 100–103. [Google Scholar] [CrossRef]
- Bishop, E.G.; Leigh, S.J. Using Large-Scale Additive Manufacturing (LSAM) as a Bridge Manufacturing Process in Response to Shortages in PPE during the COVID-19 Outbreak. Int. J. Bioprinting 2020, 6, 51–58. [Google Scholar] [CrossRef] [PubMed]
- Son, K.; Lee, J.H.; Lee, K.B. Comparison of Intaglio Surface Trueness of Interim Dental Crowns Fabricated with Sla 3d Printing, Dlp 3d Printing, and Milling Technologies. Healthcare 2021, 9, 983. [Google Scholar] [CrossRef] [PubMed]
- Meghana, S.; Kabra, P.; Chakraborty, S.; Padmavathy, N. Understanding the pathway of antibacterial activity of copper oxide nanoparticles. RSC Adv. 2015, 5, 12293–12299. [Google Scholar] [CrossRef]
- Bezza, F.A.; Tichapondwa, S.M.; Chirwa, E.M.N. Fabrication of monodispersed copper oxide nanoparticles with potential application as antimicrobial agents. Sci. Rep. 2020, 10, 16680. [Google Scholar] [CrossRef]
- Bouzakis, K.D.; Vidakis, N. Superficial plastic response determination of hard isotropic materials using ball indentations and a FEM optimization technique. Mater. Charact. 1999, 42, 1–12. [Google Scholar] [CrossRef]
- Papi, M.; Palmieri, V.; Bugli, F.; De Spirito, M.; Sanguinetti, M.; Ciancico, C.; Braidotti, M.C.; Gentilini, S.; Angelani, L.; Conti, C. Biomimetic antimicrobial cloak by graphene-oxide agar hydrogel. Sci. Rep. 2016, 6, 1–7. [Google Scholar] [CrossRef] [Green Version]

Publisher’s Note: MDPI stays neutral with regard to jurisdictional claims in published maps and institutional affiliations. |
© 2022 by the authors. Licensee MDPI, Basel, Switzerland. This article is an open access article distributed under the terms and conditions of the Creative Commons Attribution (CC BY) license (https://creativecommons.org/licenses/by/4.0/).
Share and Cite
Petousis, M.; Vidakis, N.; Velidakis, E.; Kechagias, J.D.; David, C.N.; Papadakis, S.; Mountakis, N. Affordable Biocidal Ultraviolet Cured Cuprous Oxide Filled Vat Photopolymerization Resin Nanocomposites with Enhanced Mechanical Properties. Biomimetics 2022, 7, 12. https://doi.org/10.3390/biomimetics7010012
Petousis M, Vidakis N, Velidakis E, Kechagias JD, David CN, Papadakis S, Mountakis N. Affordable Biocidal Ultraviolet Cured Cuprous Oxide Filled Vat Photopolymerization Resin Nanocomposites with Enhanced Mechanical Properties. Biomimetics. 2022; 7(1):12. https://doi.org/10.3390/biomimetics7010012
Chicago/Turabian StylePetousis, Markos, Nectarios Vidakis, Emmanuel Velidakis, John D. Kechagias, Constantine N. David, Stefanos Papadakis, and Nikolaos Mountakis. 2022. "Affordable Biocidal Ultraviolet Cured Cuprous Oxide Filled Vat Photopolymerization Resin Nanocomposites with Enhanced Mechanical Properties" Biomimetics 7, no. 1: 12. https://doi.org/10.3390/biomimetics7010012
APA StylePetousis, M., Vidakis, N., Velidakis, E., Kechagias, J. D., David, C. N., Papadakis, S., & Mountakis, N. (2022). Affordable Biocidal Ultraviolet Cured Cuprous Oxide Filled Vat Photopolymerization Resin Nanocomposites with Enhanced Mechanical Properties. Biomimetics, 7(1), 12. https://doi.org/10.3390/biomimetics7010012






_Kechagias.jpg)
